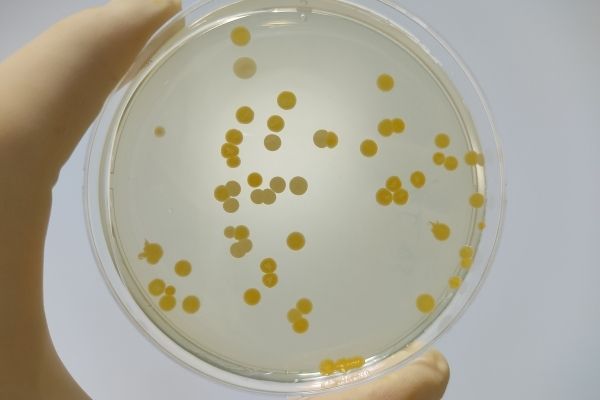

Deadline: 15-May-22
The Microbial Resource Research Infrastructure (MIRRI) second call for Transnational Access (TNA) programme is now open to promote transnational cooperation and mobility of researchers throughout pan-European research infrastructures.
Research institutions and companies in the fields of Agro-Food, Environment & Energy and Health & Food are welcome to apply for funded access to high-quality microbial resources and services, or to state-of-the-art facilities and technological platforms provided by the IS_MIRRI21 partners across Europe.
In this 2nd TNA Call, 9 IS_MIRRI21 partners offer on-site and remote access to:
- 6 experimental facilities
- 4 services
- a wide variety of microbial resources
Along with the expertise of the Access Providers’ staff to conduct scientific studies.
Eligibility Criteria
Eligibility of proposals will be assessed upon the following criteria:
- The access must be trans-national for selected ‘users’, i.e., users must apply for access in a country other than the one of their home institutions
- PhD students, postdocs, researchers, or research engineers working/studying in recognised academic or research institutions, non-profit organisations or biotechnology companies can apply for the TNA. Early career researchers, multidisciplinary proposals and applicants from non-microbiology fields are also encouraged to apply
- Master and bachelor students are not eligible
- The call is open to worldwide applications, but limited to 20% of the total participants for residents in non-EU countries
- Access is funded for a period no longer than 30 days, including weekends
- Visits must be carried out from the signature of the contract to November 2022 included
- The applicants must have an active contract with their home institution by the period of the access
- The applicants must have the complete support and validation of their home institution
- Only proposals submitted before the call deadline will be accepted
For more information, visit https://ismirri21.mirri.org/2022/02/07/now-open-the-second-tna-call/